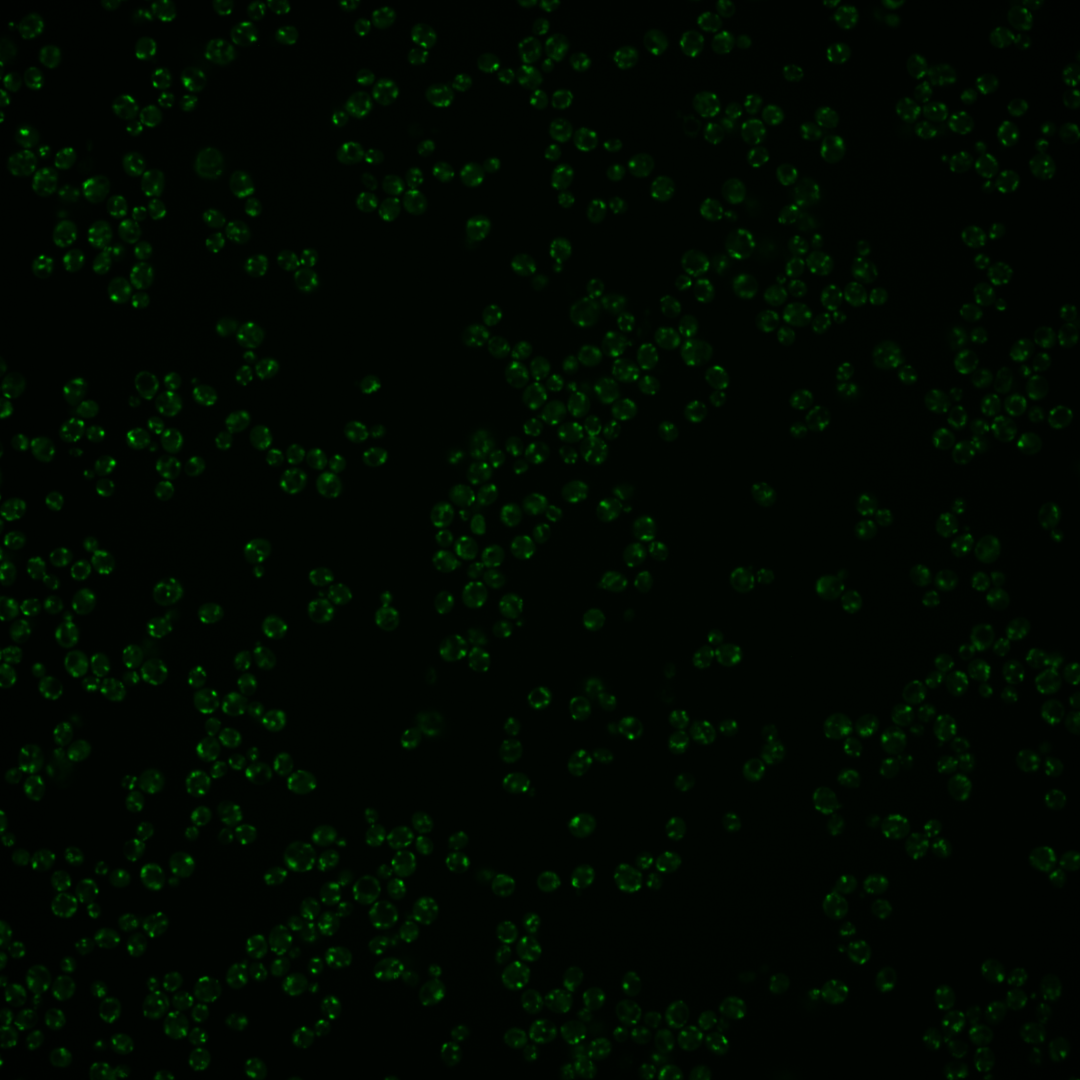

| Standard name | |
|---|---|
| Human Ortholog | |
| Description | Protein that regulates Arf1p, Arf2p to facilitate Golgi trafficking; binds phosphatidylinositol 4-phosphate, which plays a role in TGN localization; has homology to gamma-adaptin; GGA2 has a paralog, GGA1, that arose from the whole genome duplication |
Micrographs




















































































Sub-cellular Localization
Yeast GFP Assignment
Protein Abundance
Localization Change
External localization resources
| ensLOC | DeepLoc | |||||||||||||||||||||||
|---|---|---|---|---|---|---|---|---|---|---|---|---|---|---|---|---|---|---|---|---|---|---|---|---|
| Localization | WT1 | WT2 | WT3 | RAP60 | RAP140 | RAP220 | RAP300 | RAP380 | RAP460 | RAP540 | RAP620 | RAP700 | HU80 | HU120 | HU160 | rpd3Δ_1 | rpd3Δ_2 | rpd3Δ_3 | WT1 | WT2 | WT3 | AF100 | AF140 | AF180 |
| Cortical Patches | 18 | 15 | – | 9 | 16 | 12 | 15 | – | 12 | 8 | 5 | 16 | – | 6 | 7 | 55 | 61 | 53 | 14 | 9 | 0 | 0 | 1 | 5 |
| Bud | 1 | 0 | – | 1 | 0 | 2 | 5 | – | 4 | 10 | 4 | 8 | – | 0 | 0 | 2 | 3 | 2 | 0 | 0 | 1 | 0 | 1 | 1 |
| Bud Neck | 0 | 0 | – | 0 | 0 | 0 | 1 | – | 0 | 0 | 0 | 0 | – | 0 | 0 | 0 | 0 | 0 | 0 | 0 | 0 | 0 | 0 | 0 |
| Bud Site | 0 | 0 | – | 0 | 0 | 0 | 0 | – | 0 | 2 | 3 | 4 | – | 0 | 0 | 0 | 0 | 0 | – | – | – | – | – | – |
| Cell Periphery | 0 | 0 | – | 0 | 0 | 1 | 0 | – | 1 | 1 | 1 | 2 | – | 0 | 0 | 3 | 3 | 1 | 0 | 0 | 0 | 0 | 0 | 0 |
| Cytoplasm | 0 | 4 | – | 3 | 8 | 3 | 5 | – | 7 | 10 | 6 | 4 | – | 1 | 11 | 13 | 6 | 14 | 0 | 1 | 0 | 0 | 0 | 0 |
| Endoplasmic Reticulum | 1 | 2 | – | 0 | 1 | 0 | 0 | – | 0 | 2 | 0 | 0 | – | 4 | 2 | 9 | 4 | 10 | 0 | 0 | 0 | 0 | 0 | 0 |
| Endosome | 5 | 1 | – | 2 | 5 | 5 | 14 | – | 9 | 10 | 4 | 11 | – | 2 | 5 | 2 | 2 | 4 | 12 | 15 | 2 | 1 | 6 | 8 |
| Golgi | 64 | 92 | – | 62 | 151 | 59 | 77 | – | 18 | 32 | 6 | 7 | – | 30 | 88 | 278 | 300 | 286 | 175 | 110 | 16 | 15 | 47 | 112 |
| Mitochondria | 189 | 100 | – | 87 | 85 | 137 | 173 | – | 133 | 142 | 139 | 145 | – | 21 | 25 | 38 | 22 | 29 | 9 | 10 | 2 | 0 | 2 | 3 |
| Nucleus | 0 | 0 | – | 0 | 0 | 0 | 3 | – | 1 | 0 | 2 | 1 | – | 0 | 0 | 0 | 0 | 0 | 0 | 0 | 0 | 0 | 1 | 0 |
| Nuclear Periphery | 3 | 0 | – | 0 | 0 | 0 | 5 | – | 2 | 2 | 2 | 2 | – | 0 | 0 | 0 | 0 | 1 | 0 | 0 | 0 | 0 | 0 | 0 |
| Nucleolus | 35 | 10 | – | 7 | 15 | 20 | 48 | – | 24 | 30 | 34 | 26 | – | 8 | 2 | 21 | 45 | 34 | 2 | 2 | 0 | 0 | 0 | 0 |
| Peroxisomes | 3 | 0 | – | 2 | 5 | 6 | 9 | – | 4 | 7 | 6 | 12 | – | 0 | 1 | 2 | 0 | 0 | 12 | 8 | 1 | 0 | 0 | 1 |
| SpindlePole | 0 | 0 | – | 0 | 1 | 2 | 4 | – | 2 | 3 | 3 | 11 | – | 0 | 3 | 1 | 1 | 3 | 4 | 0 | 0 | 0 | 0 | 0 |
| Vac/Vac Membrane | 9 | 17 | – | 5 | 13 | 5 | 7 | – | 8 | 8 | 2 | 5 | – | 3 | 5 | 26 | 25 | 30 | 4 | 9 | 1 | 0 | 2 | 5 |
| Unique Cell Count | 223 | 155 | 112 | 202 | 188 | 276 | 175 | 212 | 165 | 198 | 49 | 115 | 330 | 373 | 345 | 238 | 170 | 30 | 19 | 68 | 140 | |||
| Labelled Cell Count | 328 | 241 | 178 | 300 | 252 | 366 | 225 | 267 | 217 | 254 | 75 | 149 | 450 | 472 | 467 | 238 | 170 | 30 | 19 | 68 | 140 | |||
Yeast GFP Assignment
Protein Abundance
| Screen | WT1 | WT2 | WT3 | RAP60 | RAP140 | RAP220 | RAP300 | RAP380 | RAP460 | RAP540 | RAP620 | RAP700 | HU80 | HU120 | HU160 | rpd3Δ_1 | rpd3Δ_2 | rpd3Δ_3 | AF100 | AF140 | AF180 |
|---|---|---|---|---|---|---|---|---|---|---|---|---|---|---|---|---|---|---|---|---|---|
| Mean Cell GFP Intensity (1e-4) | 19.9 | 26.2 | – | 18.7 | 19.9 | 17.1 | 16.2 | – | 12.9 | 13.3 | 11.0 | 11.8 | – | 18.9 | 18.1 | 28.9 | 27.5 | 27.6 | – | 15.1 | 18.9 |
| Std Deviation (1e-4) | 3.0 | 4.8 | – | 3.4 | 3.6 | 2.9 | 3.1 | – | 2.8 | 3.0 | 2.5 | 2.7 | – | 5.2 | 4.3 | 6.8 | 5.9 | 6.4 | – | 3.5 | 4.2 |
| Intensity Change (Log2) | – | – | – | – | – | – | – | – | – | – | – | – | – | – | – | – | – | – | – | – | – |
Localization Change
| Localization | RAP60 | RAP140 | RAP220 | RAP300 | RAP380 | RAP460 | RAP540 | RAP620 | RAP700 | HU80 | HU120 | HU160 | rpd3Δ_1 | rpd3Δ_2 | rpd3Δ_3 |
|---|---|---|---|---|---|---|---|---|---|---|---|---|---|---|---|
| Actin | – | – | – | – | – | – | – | – | – | – | – | – | – | – | – |
| Bud | – | – | – | – | – | – | – | – | – | – | – | – | – | – | – |
| Bud Neck | – | – | – | – | – | – | – | – | – | – | – | – | – | – | – |
| Bud Site | – | – | – | – | – | – | – | – | – | – | – | – | – | – | – |
| Cell Periphery | – | – | – | – | – | – | – | – | – | – | – | – | – | – | – |
| Cyto | – | – | – | – | – | – | – | – | – | – | – | – | – | – | – |
| Endoplasmic Reticulum | – | – | – | – | – | – | – | – | – | – | – | – | – | – | – |
| Endosome | – | – | – | – | – | – | – | – | – | – | – | – | – | – | – |
| Golgi | – | – | – | – | – | – | – | – | – | – | – | – | – | – | – |
| Mitochondria | – | – | – | – | – | – | – | – | – | – | – | – | – | – | – |
| Nuclear Periphery | – | – | – | – | – | – | – | – | – | – | – | – | – | – | – |
| Nuc | – | – | – | – | – | – | – | – | – | – | – | – | – | – | – |
| Nucleolus | – | – | – | – | – | – | – | – | – | – | – | – | – | – | – |
| Peroxisomes | – | – | – | – | – | – | – | – | – | – | – | – | – | – | – |
| SpindlePole | – | – | – | – | – | – | – | – | – | – | – | – | – | – | – |
| Vac | – | – | – | – | – | – | – | – | – | – | – | – | – | – | – |
| Cortical Patches | – | – | – | – | – | – | – | – | – | – | – | – | – | – | – |
| Cytoplasm | – | – | – | – | – | – | – | – | – | – | – | – | – | – | – |
| Nucleus | – | – | – | – | – | – | – | – | – | – | – | – | – | – | – |
| Vacuole | – | – | – | – | – | – | – | – | – | – | – | – | – | – | – |
External localization resources
Images






























Protein Concentration and Protein Localization Data
| R1 | R2 | R3 | ||||||||||||||||
|---|---|---|---|---|---|---|---|---|---|---|---|---|---|---|---|---|---|---|
| G1 Pre-START | G1 Post-START | S/G2 | Metaphase | Anaphase | Telophase | G1 Pre-START | G1 Post-START | S/G2 | Metaphase | Anaphase | Telophase | G1 Pre-START | G1 Post-START | S/G2 | Metaphase | Anaphase | Telophase | |
| Concentration | 11.7074 | 15.8974 | 14.1408 | 13.4043 | 10.7836 | 14.2941 | 12.9636 | 17.1359 | 15.5737 | 15.4456 | 12.7423 | 16.3461 | 11.2408 | 14.9865 | 13.772 | 13.3901 | 8.1585 | 14.3233 |
| Actin | 0.0287 | 0.0159 | 0.0225 | 0.018 | 0.0768 | 0.0051 | 0.0268 | 0.0214 | 0.0177 | 0.0031 | 0.0044 | 0.019 | 0.0315 | 0.0194 | 0.0354 | 0.0211 | 0.1135 | 0.004 |
| Bud | 0.0004 | 0.0005 | 0.0003 | 0.0017 | 0.0005 | 0.0002 | 0.0006 | 0.0009 | 0.0002 | 0.0002 | 0.0005 | 0.0001 | 0.0008 | 0.0013 | 0.0004 | 0.0006 | 0.0004 | 0.0001 |
| Bud Neck | 0.0011 | 0.0006 | 0.0004 | 0.0007 | 0.0012 | 0.0003 | 0.0009 | 0.0006 | 0.0004 | 0.0002 | 0.0005 | 0.0005 | 0.012 | 0.0005 | 0.0035 | 0.0004 | 0.0218 | 0.0003 |
| Bud Periphery | 0.0005 | 0.0003 | 0.0003 | 0.0021 | 0.0004 | 0.0002 | 0.0008 | 0.0007 | 0.0002 | 0.0003 | 0.0008 | 0.0002 | 0.0009 | 0.0013 | 0.0003 | 0.0005 | 0.0004 | 0.0001 |
| Bud Site | 0.0037 | 0.003 | 0.0008 | 0.0046 | 0.0062 | 0.0001 | 0.0037 | 0.004 | 0.0014 | 0.0002 | 0.0014 | 0.0002 | 0.0084 | 0.0055 | 0.0054 | 0.0021 | 0.002 | 0.0001 |
| Cell Periphery | 0.0002 | 0.0004 | 0.0001 | 0.0002 | 0.0002 | 0.0001 | 0.0005 | 0.0002 | 0.0002 | 0.0001 | 0.0003 | 0.0002 | 0.0003 | 0.0003 | 0.0002 | 0.0002 | 0.0002 | 0.0001 |
| Cytoplasm | 0.0015 | 0.0014 | 0.0014 | 0.0006 | 0.0068 | 0.0033 | 0.0019 | 0.0011 | 0.0013 | 0.0006 | 0.0022 | 0.0003 | 0.0034 | 0.0018 | 0.0017 | 0.0015 | 0.0009 | 0.0002 |
| Cytoplasmic Foci | 0.0581 | 0.0793 | 0.0537 | 0.0391 | 0.0846 | 0.0278 | 0.0445 | 0.0601 | 0.038 | 0.0435 | 0.0497 | 0.0176 | 0.0534 | 0.0489 | 0.0419 | 0.0381 | 0.0728 | 0.0157 |
| Eisosomes | 0.0002 | 0.0001 | 0.0001 | 0.0001 | 0.0002 | 0 | 0.0003 | 0.0001 | 0.0003 | 0.0001 | 0.0002 | 0.0001 | 0.0004 | 0.0001 | 0.0003 | 0.0003 | 0.0002 | 0.0001 |
| Endoplasmic Reticulum | 0.0016 | 0.0003 | 0.0007 | 0.0004 | 0.0033 | 0.0003 | 0.0021 | 0.0003 | 0.0007 | 0.0015 | 0.0011 | 0.0004 | 0.002 | 0.0002 | 0.0008 | 0.0027 | 0.0005 | 0.0003 |
| Endosome | 0.1534 | 0.1783 | 0.1481 | 0.2357 | 0.1644 | 0.1 | 0.1855 | 0.1697 | 0.1465 | 0.2251 | 0.151 | 0.0804 | 0.1273 | 0.1572 | 0.1382 | 0.1719 | 0.1913 | 0.0822 |
| Golgi | 0.5766 | 0.6144 | 0.6546 | 0.5966 | 0.5485 | 0.7984 | 0.5642 | 0.6179 | 0.6518 | 0.6292 | 0.5391 | 0.7372 | 0.5854 | 0.6713 | 0.6697 | 0.6557 | 0.3972 | 0.797 |
| Lipid Particles | 0.0368 | 0.0352 | 0.0243 | 0.0427 | 0.029 | 0.0125 | 0.0529 | 0.0332 | 0.0381 | 0.0311 | 0.079 | 0.0512 | 0.0383 | 0.031 | 0.0305 | 0.0356 | 0.0663 | 0.0201 |
| Mitochondria | 0.1041 | 0.0396 | 0.0649 | 0.0395 | 0.0431 | 0.0423 | 0.0699 | 0.0566 | 0.0568 | 0.0454 | 0.1275 | 0.0572 | 0.0885 | 0.0318 | 0.0475 | 0.0228 | 0.0027 | 0.0575 |
| None | 0.0009 | 0 | 0.0004 | 0.0001 | 0.0026 | 0.002 | 0.0026 | 0.0001 | 0.0029 | 0.0003 | 0.0066 | 0.0001 | 0.01 | 0.0001 | 0.0017 | 0.0011 | 0.0004 | 0 |
| Nuclear Periphery | 0.0022 | 0.0001 | 0.0048 | 0.0002 | 0.002 | 0.0002 | 0.0051 | 0.0001 | 0.0008 | 0.0024 | 0.0027 | 0.0015 | 0.0048 | 0.0001 | 0.0012 | 0.0031 | 0.0003 | 0.0001 |
| Nucleolus | 0.0003 | 0.004 | 0.0003 | 0.0002 | 0.0005 | 0.0004 | 0.0047 | 0.0002 | 0.0082 | 0.0002 | 0.0006 | 0.0006 | 0.0013 | 0.0003 | 0.0004 | 0.0008 | 0.0004 | 0.0001 |
| Nucleus | 0.0004 | 0.0005 | 0.0018 | 0.0001 | 0.001 | 0.0007 | 0.0013 | 0.0001 | 0.0005 | 0.0003 | 0.0005 | 0.0002 | 0.0021 | 0.0002 | 0.0004 | 0.0009 | 0.0002 | 0 |
| Peroxisomes | 0.0152 | 0.0146 | 0.0083 | 0.0068 | 0.0147 | 0.0019 | 0.0122 | 0.0181 | 0.0142 | 0.0041 | 0.0075 | 0.0034 | 0.0125 | 0.0046 | 0.0108 | 0.0071 | 0.1141 | 0.0159 |
| Punctate Nuclear | 0.0015 | 0.0002 | 0.0018 | 0.0004 | 0.0045 | 0.0001 | 0.0013 | 0.0002 | 0.0011 | 0.0006 | 0.0008 | 0.0003 | 0.0062 | 0.0001 | 0.001 | 0.0013 | 0.004 | 0 |
| Vacuole | 0.0066 | 0.0068 | 0.0044 | 0.0035 | 0.005 | 0.0013 | 0.0075 | 0.0047 | 0.0065 | 0.0045 | 0.0091 | 0.0077 | 0.0041 | 0.0139 | 0.0039 | 0.0158 | 0.0033 | 0.0017 |
| Vacuole Periphery | 0.0058 | 0.0046 | 0.0061 | 0.0069 | 0.0045 | 0.0027 | 0.0108 | 0.0095 | 0.0124 | 0.0071 | 0.0146 | 0.0216 | 0.0063 | 0.0103 | 0.0049 | 0.0163 | 0.0071 | 0.0046 |
Sequencing Data
| R1 | R2 | |||||||||
|---|---|---|---|---|---|---|---|---|---|---|
| G1 Post-START | S/G2 | Metaphase | Anaphase | Telophase | G1 Post-START | S/G2 | Metaphase | Anaphase | Telophase | |
| Gene Expression | 95.4024 | 103.7995 | 76.191 | 85.6261 | 98.4665 | 86.5674 | 106.228 | 99.3608 | 82.2453 | 97.1368 |
| Translational Efficiency | 1.2341 | 1.1785 | 1.1544 | 0.9349 | 1.125 | 1.6379 | 1.1781 | 1.2402 | 1.3428 | 1.3312 |
Hit Data
| Dataset | Hit |
|---|---|
| Protein Concentration | ✘ |
| Protein Localization | ✘ |
| Gene Expression | ✔ |
| Translational Efficiency | ✘ |
Endocytosis
| Temp | Actin Patch (Sac6-tdTomato) | Cortical Patch (Sla1-GFP) | Late Endosome (Snf7-GFP) | Vacuole (Vph1-GFP) |
|---|---|---|---|---|
| 37℃ | ||||
| RT |
Cell Cycle Omics
CYCLoPs (Gga2-GFP)
| Gene / Allele | Actin Patch (Sac6-tdTomato) | Cortical Patch (Sla1-GFP) | Late Endosome (Snf7-GFP) | Vacuole (Sac6-tdTomato) |
|---|
| Gene | Images |
|---|
| Gene | Images |
|---|
Images are not yet available
Images are not yet available